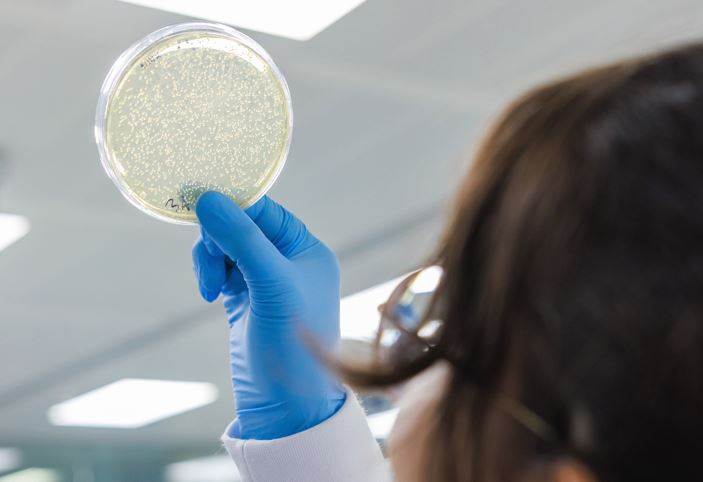
Former Invista CTO backs Epoch’s plastic-eating enzymes

Former Invista CTO backs Epoch’s plastic-eating enzymes
Epoch Biodesign, a UK-based company tackling nylon 6,6 waste with biorecycling enzyme technology, has appointed former Invista chief technology officer Jerry Grunewald as a senior advisor.
At Invista, Mr Grunewald held leadership roles spanning R&D, technology and operations across 13 operating sites, over a 36-year career.
Epoch is using the capital from a recent fundraising to build its first commercial plant and expand its library of plastic-eating enzymes. Its target will be nylon 6,6 blends, and the company aims to process tens of thousands of tonnes of waste by 2028.
Jacob Nathan, founder and CEO of Epoch Biodesign, said: "Jerry's deep understanding of polymer chemistry and industrial-scale manufacturing is exactly what we need as we build our first commercial facility.”
Jerry Grunewald added: “The Epoch approach works at lower temperatures which minimises degradation and byproducts. If you end up with impurities, there is more potential to create a second-grade material that can't be used for high-quality applications like airbag fibres or automotive parts. The Epoch process has the opportunity to produce materials that can meet these exacting standards and that is a huge step forward.”










